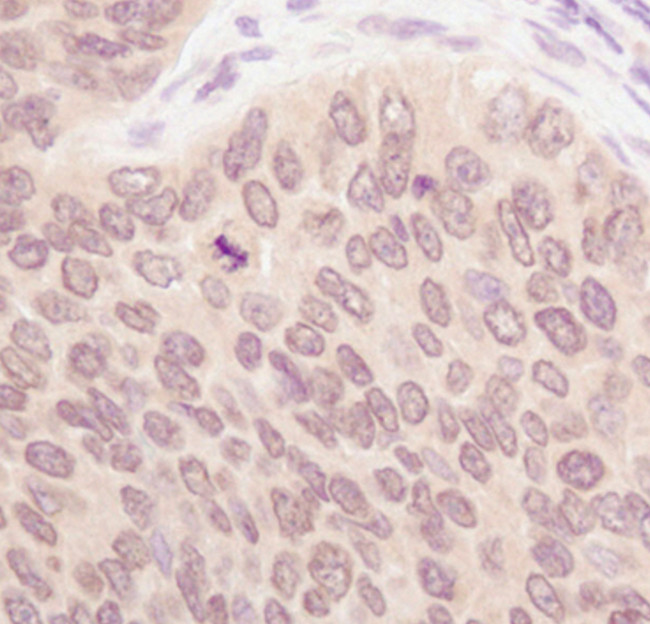
SUMO1 Antibody in Immunohistochemistry (Paraffin) (IHC (P))

Search
Invitrogen
SUMO1 Polyclonal Antibody
{{$productOrderCtrl.translations['antibody.pdp.commerceCard.promotion.promotions']}}
{{$productOrderCtrl.translations['antibody.pdp.commerceCard.promotion.viewpromo']}}
{{$productOrderCtrl.translations['antibody.pdp.commerceCard.promotion.promocode']}}: {{promo.promoCode}} {{promo.promoTitle}} {{promo.promoDescription}}. {{$productOrderCtrl.translations['antibody.pdp.commerceCard.promotion.learnmore']}}


Please note: We are reviewing Western blot images included in the antibody testing data in our catalog, including those provided by third parties. Unless expressly labeled or annotated as “raw-unedited”, Western blot images included in the antibody testing data in our catalog may have been edited, optimized or otherwise adjusted for presentation.
产品信息
PA5-17352
种属反应
宿主/亚型
分类
类型
抗原
偶联物
形式
浓度
规格
纯化类型
保存液
内含物
保存条件
运输条件
RRID
产品详细信息
It is not recommended to aliquot this antibody.
靶标信息
SUMO1 is an ubiquitin-like protein that can be covalently attached to proteins as a monomer or a lysine-linked polymer. Covalent attachment, via an isopeptide bond, to its substrates requires prior activation by the E1 complex SAE1-SAE2 and linkage to the E2 enzyme UBE2I, and can be promoted by E3 ligases such as PIAS1-4, RANBP2 or CBX4. This post-translational modification on lysine residues of proteins plays a crucial role in a number of cellular processes such as nuclear transport, DNA replication and repair, mitosis and signal transduction. SUMO1 is involved, for instance, in targeting RANGAP1 to the nuclear pore complex protein RANBP2. Polymeric SUMO1 chains are also susceptible to polyubiquitination which functions as a signal for proteasomal degradation of modified proteins. SUMO1 may also regulate a network of genes involved in palate development. Mutations in the gene can result in non-syndromic orofacial cleft 10.
仅用于科研。不用于诊断过程。未经明确授权不得转售。
篇参考文献 (0)
生物信息学
蛋白别名: CG4494-PA; GAP-modifying protein 1; GMP1; LD07775p; OTTHUMP00000202403; OTTHUMP00000202404; OTTHUMP00000202405; OTTHUMP00000202406; OTTHUMP00000202409; OTTHUMP00000202410; Sentrin; Sentrin-1; Small ubiquitin-related modifier 1; small ubiquitin-related modifier-1; SMT3 homolog 3; SMT3 suppressor of mif two 3 homolog 1; Smt3C; SUMO-1; SUMO-1 related peptidase; Ubiquitin-homology domain protein PIC1; ubiquitin-like 1; ubiquitin-like 1 (sentrin); Ubiquitin-like protein SMT3C; Ubiquitin-like protein UBL1
基因别名: GMP1; OK/SW-cl.43; PIC1; SENTRIN; SMT3; SMT3C; SMT3H3; SMTP3; SUMO-1; SUMO1; UBL1
UniProt ID: (Mouse) P63166, (Rat) Q5I0H3
Entrez Gene ID: (Mouse) 22218, (Rat) 301442